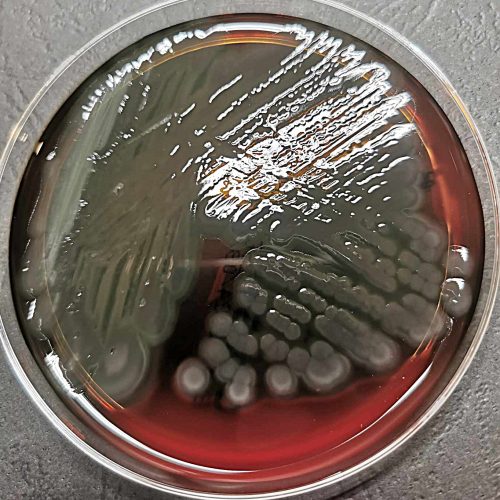
pseudomonas-aeruginosa-zdj-3
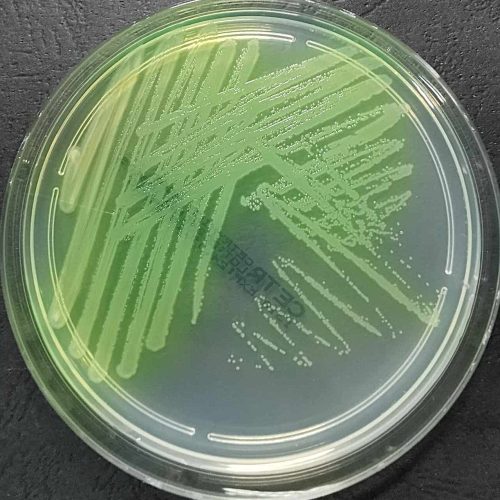
pseudomonas-aeruginosa-zdj-2
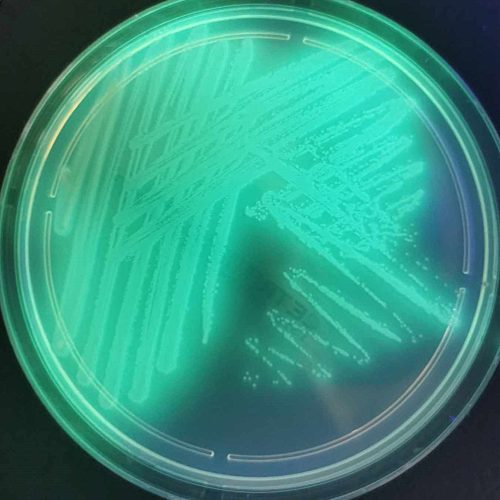
pseudomonas-aeruginosa-zdj-1

Jaszczurki, podobnie jak inne zwierzęta i ludzie, mogą mieć kontakt z różnymi bakteriami. Jedną z nich jest Pseudomonas aeruginosa, bakteria Gram-ujemna występująca powszechnie w środowisku, a zwłaszcza w wodzie i glebie.
Jaki jest wpływ bakterii na jaszczurki?
Pseudomonas aeruginosa może powodować u jaszczurek różnorodne zakażenia m.in. infekcje skóry, oczu, dróg oddechowych, a nawet układu pokarmowego.
Czy wiesz, że Pseudomonas aeruginosa stanowi 34%* wszystkich bakterii izolowanych ze zmian skórnych od jaszczurek?
*dane statystyczne na postawie badań prowadzonych w Laboratorium Vetlab w latach 2020-2024.
Co sprawia, że ta bakteria jest taka groźna?
- Biofilm – struktura, którą stanowi kilkadziesiąt warstw bakterii otoczonych jeszcze dodatkową substancją. Zapewnia on niczym super tarcza ochronę przed czynnikami zewnętrznymi, w tym antybiotykami i działaniem układu odpornościowego. Biofilmy są niezwykle trudne do usunięcia i często prowadzą do przewlekłych infekcji.
- Quorum sensing – jest to mechanizm pozwalający komórkom bakteryjnym na komunikację między sobą poprzez sygnały chemiczne. Dzięki tej komunikacji bakterie, działając niczym zorganizowana grupa przestępcza, mogą zmieniać swoją liczebność, kontrolować produkcję toksyn i mechanizmy chroniące przed antybiotykami.
- Oporność na antybiotyki – Pseudomonas aeruginosa, niczym super złoczyńca, posiada naturalną oporność na ogromną liczbę antybiotyków. Bakteria ta jest oporna na m.in penicylinę G, aminopenicyliny, cefalosporyny I i II generacji, chloramfenikol, tetracykliny, sulfametoksazol+trimetoprim, makrolidy, linkozamidy.
- Fluorescencja – charakterystyczną cechą tej bakterii jest produkcja barwników fluorescencyjnych m.in. piocyjaniny, piowerdyny. Barwniki te emitują światło pod wpływem promieniowania ultrafioletowego (UV), dzięki tej właściwości, kolonie na podłożach mikrobiologicznych mogą świecić w ciemności po naświetleniu UV.
Zdjęcie 3. Pseudomonas aeruginosa
Pseudomonas aeruginosa jest wszechobecna w środowisku, a jej obecność u jaszczurek może prowadzić do przewlekłych i trudnych w leczeniu infekcji. Dzięki zdolności tworzenia biofilmów, komunikacji chemicznej i oporności na wiele antybiotyków, bakteria staje się wyjątkowo trudnym przeciwnikiem.
Świadomość zagrożeń i systematyczna opieka pozwalają minimalizować ryzyko infekcji i zapewnić jaszczurkom długie, zdrowe życie.
Kategorie wpisów
- Alergologia (7)
- Biochemia (1)
- Cytologia (5)
- Hipiatria (4)
- Histopatologia (1)
- Immunologia (1)
- Mikrobiologia (2)
- Nefrologia (1)
- Parazytologia (2)